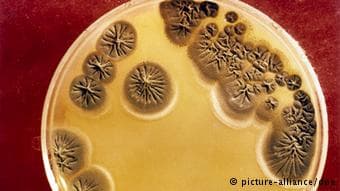
Las manos son una fuente inagotable de bacterias. Según un estudio de la Universidad de Boulder, en Colorado, se identificaron más de 4,700 especies diferentes de bacterias en las manos.

Aunque el uso de germicidas o "hand sanitizers" ha proliferado como método de lavado de manos, expertos aseguraron hoy, en el Día Mundial del Lavado de Manos, que el método correcto, más fácil y menos costoso para prevenir muchas enfermedades infecciosas es el uso del agua y el jabón.
Llamado a la higiene en el Día Mundial de Lavarse las Manos
Expertos aseguran que es mejor usar agua y jabón que gel antibacterial.

El Servicio de Extensión Agrícola de la Universidad de Puerto Rico, junto a la Organización Panamericana de la Salud (OMS) y el Departamento de Salud, se unieron para concienciar sobre el proceso correcto del lavado, que consiste en frotarse las manos con agua y jabón durante 20 segundos o mientras se canta dos veces el cumpleaños feliz.
Raúl Castellano, representante de la OMS, mencionó que enfermedades infecciosas como Salmonelosis, hepatitis A, citomegalovirus, influenza, catarro común y otras se pueden prevenir con el lavado de mano.
Sobre los problemas de racionamiento de agua que enfrentan muchos ciudadanos, Castellano recomendó separar un abasto de agua potable para lavarse las manos e insistió en no abandonar esta práctica.
Lizette Ocasio, coordinadora del proyecto de Inocuidad de Alimentos de Extensión Agrícola, dijo a la agencia Inter News Service (INS) que no hay un jabón específico para el lavado y explicó que su función es levantar el sucio.
La isla se une por primera vez al esfuerzo mundial que se celebra desde el 2008 en varios países, para educar sobre esta práctica con actividades en distintos municipios.